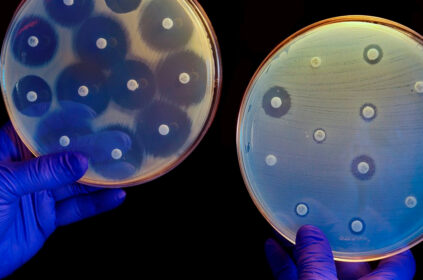

En Breve
Por: Enrique Avilés
En BREVE martes 15 de octubre 2024.- En breve te comparto que la Junta Mundial de Vigilancia de la Preparación (GPMB, por sus siglas en inglés), respaldada por la Organización Mundial de la Salud (OMS) y el Banco Mundial, ha emitido una contundente advertencia sobre la vulnerabilidad del mundo ante futuras pandemias.
En su más reciente informe, presentado durante la 15ª Cumbre Mundial de la Salud en Berlín, subrayó la necesidad urgente de replantear el enfoque global para prepararse ante brotes de enfermedades.
El informe identifica 15 factores clave de riesgo agrupados en cinco categorías: sociales, tecnológicos, medioambientales, económicos y políticos y recuerda brotes recientes de virus como el de Marburgo, y la última cepa de gripe aviar entre otras.
En lo que va de 2024, ya se han registrado 17 brotes de enfermedades graves.
El informe insta a los países a fortalecer sus sistemas de atención primaria, invertir en investigación y desarrollo.
La recomendación es no bajes la guardia, cuídate y sígueme en redes sociales @avilesenrique y nos escuchamos en breve.